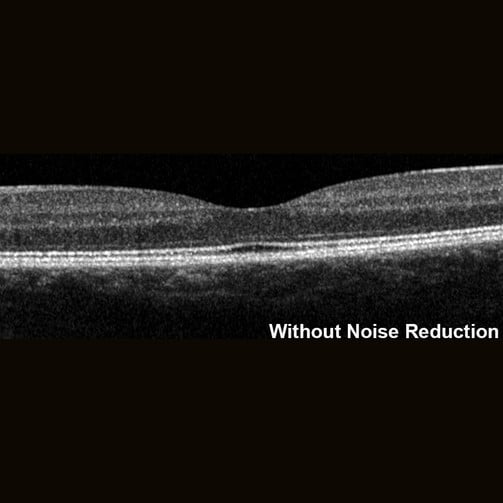
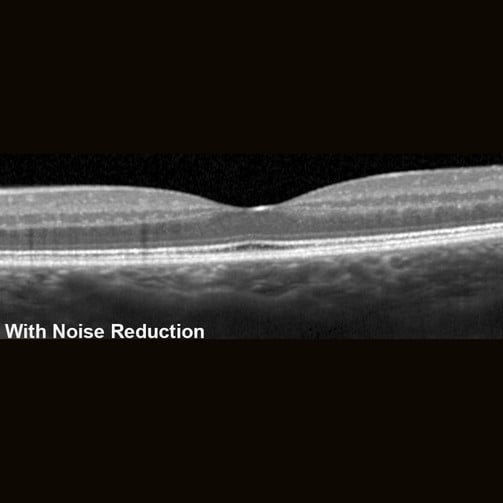

Confocal Scanning Laser Ophthalmoscopy (cSLO)
The SPECTRALIS® confocal scanning laser ophthalmoscope (cSLO) is an innovative technology for imaging the retina. The cSLO provides image detail and clarity not available from fundus photography by combining the selectivity of laser light with the pinpoint resolution of confocal scanning. Often the technology reveals critical diagnostic details not visible with traditional ophthalmoscopy, helping the clinician to document clinical findings. Since cSLO imaging minimizes the effects of light scatter, it can be used effectively even in patients with media opacities or small pupils.